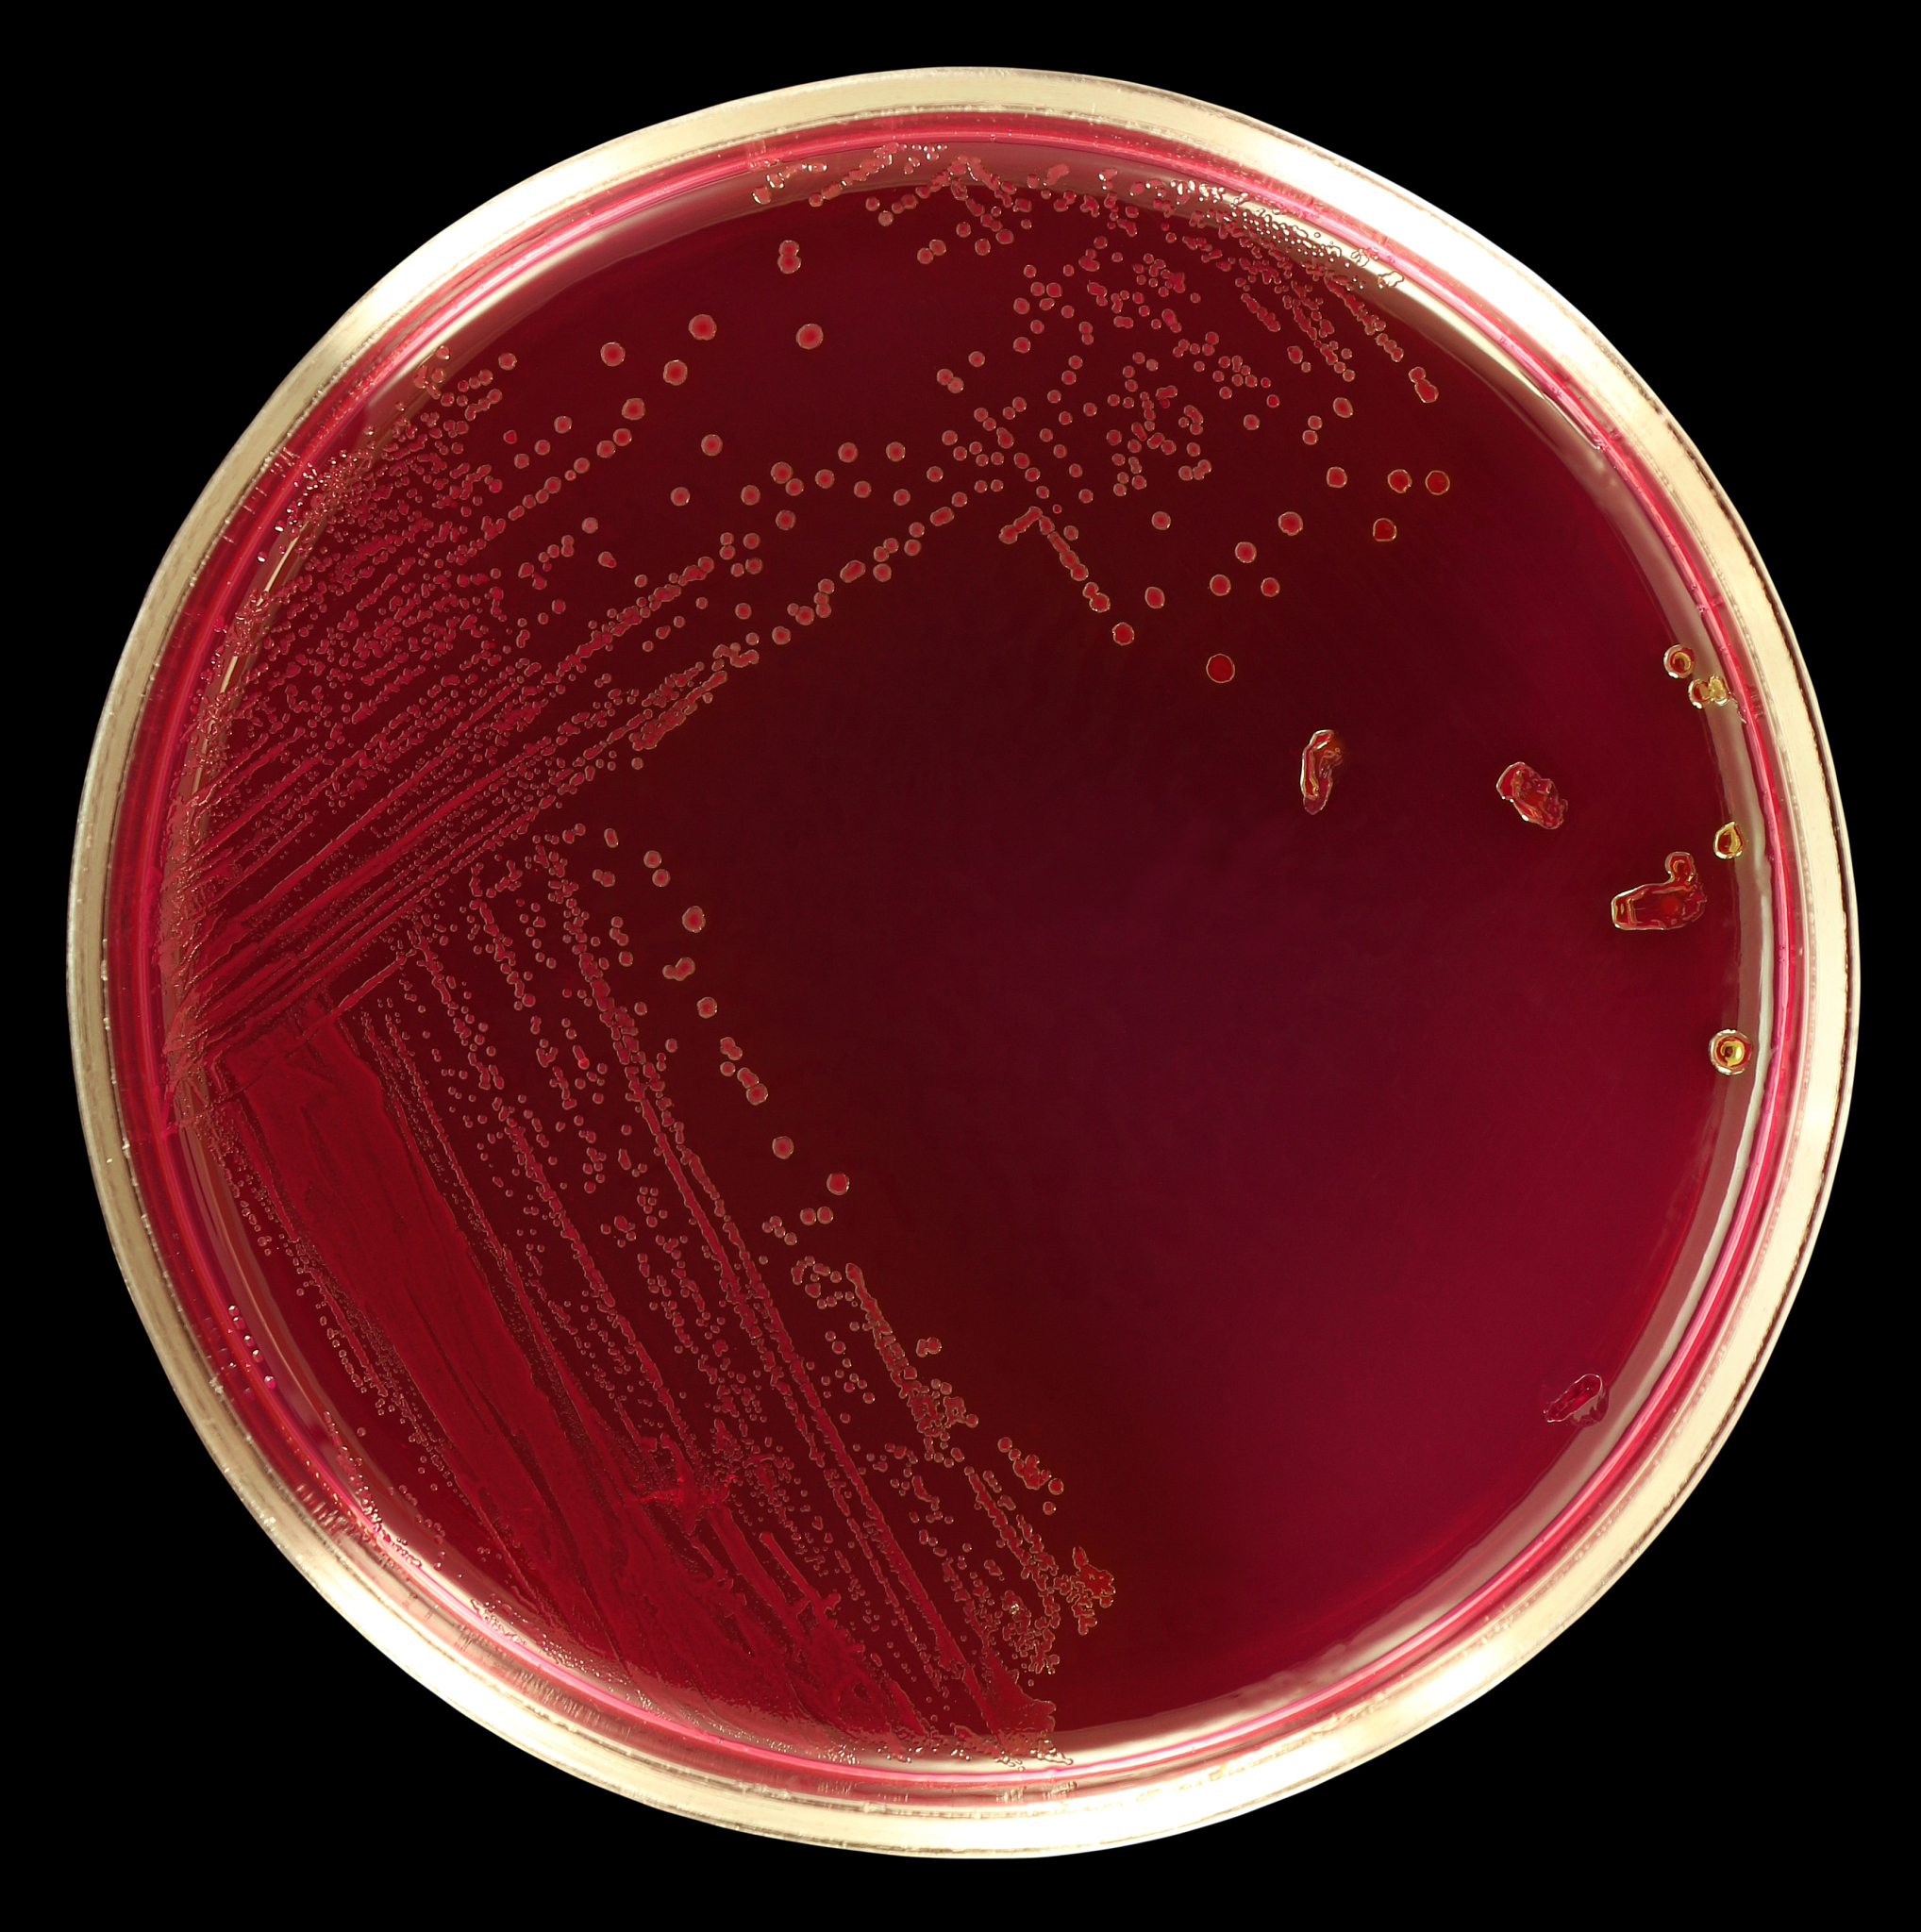
在重组大肠杆菌产β-葡萄糖苷酶发酵试验中与其他组实验结构比较所发现实验现象的异同

在重组大肠杆菌产β-葡萄糖苷酶发酵试验中与其他组实验结构比较所发现实验现象的异同
在重组大肠杆菌产β-葡萄糖苷酶发酵试验中,与其他组实验结构比较,可能发现以下异同:
异同点:
-
实验目的相同,即都是为了生产β-葡萄糖苷酶。
-
实验步骤可能有所不同,但都需要进行发酵过程。
-
实验所使用的菌种可能不同,但都是以大肠杆菌为基础。
-
实验所使用的质粒也可能不同,但都是为了将目标基因导入到大肠杆菌中。
-
实验所使用的培养基可能不同,但都需能够提供菌落生长所需的营养物质。
-
实验所使用的控制变量也可能不同,但都需要确保实验的准确性和可重复性。
不同点:
-
实验所使用的质粒类型、载体、启动子等有可能不同。
-
实验所使用的诱导剂、温度、时间等条件也可能不同。
-
实验所得到的β-葡萄糖苷酶产量和纯度可能有所不同,因为实验条件和菌株不同。
-
实验可能采用不同的检测方法和仪器进行分析和鉴定。
-
实验中使用的基因工程技术可能有所不同,如CRISPR/Cas9、TALEN、ZFN等。
总之,不同的实验结构和条件可能会对实验结果产生不同的影响。因此,需要根据实验目的和具体情况选择合适的实验结构和条件,以确保实验的准确性和可重复性
原文地址: https://www.cveoy.top/t/topic/fshe 著作权归作者所有。请勿转载和采集!